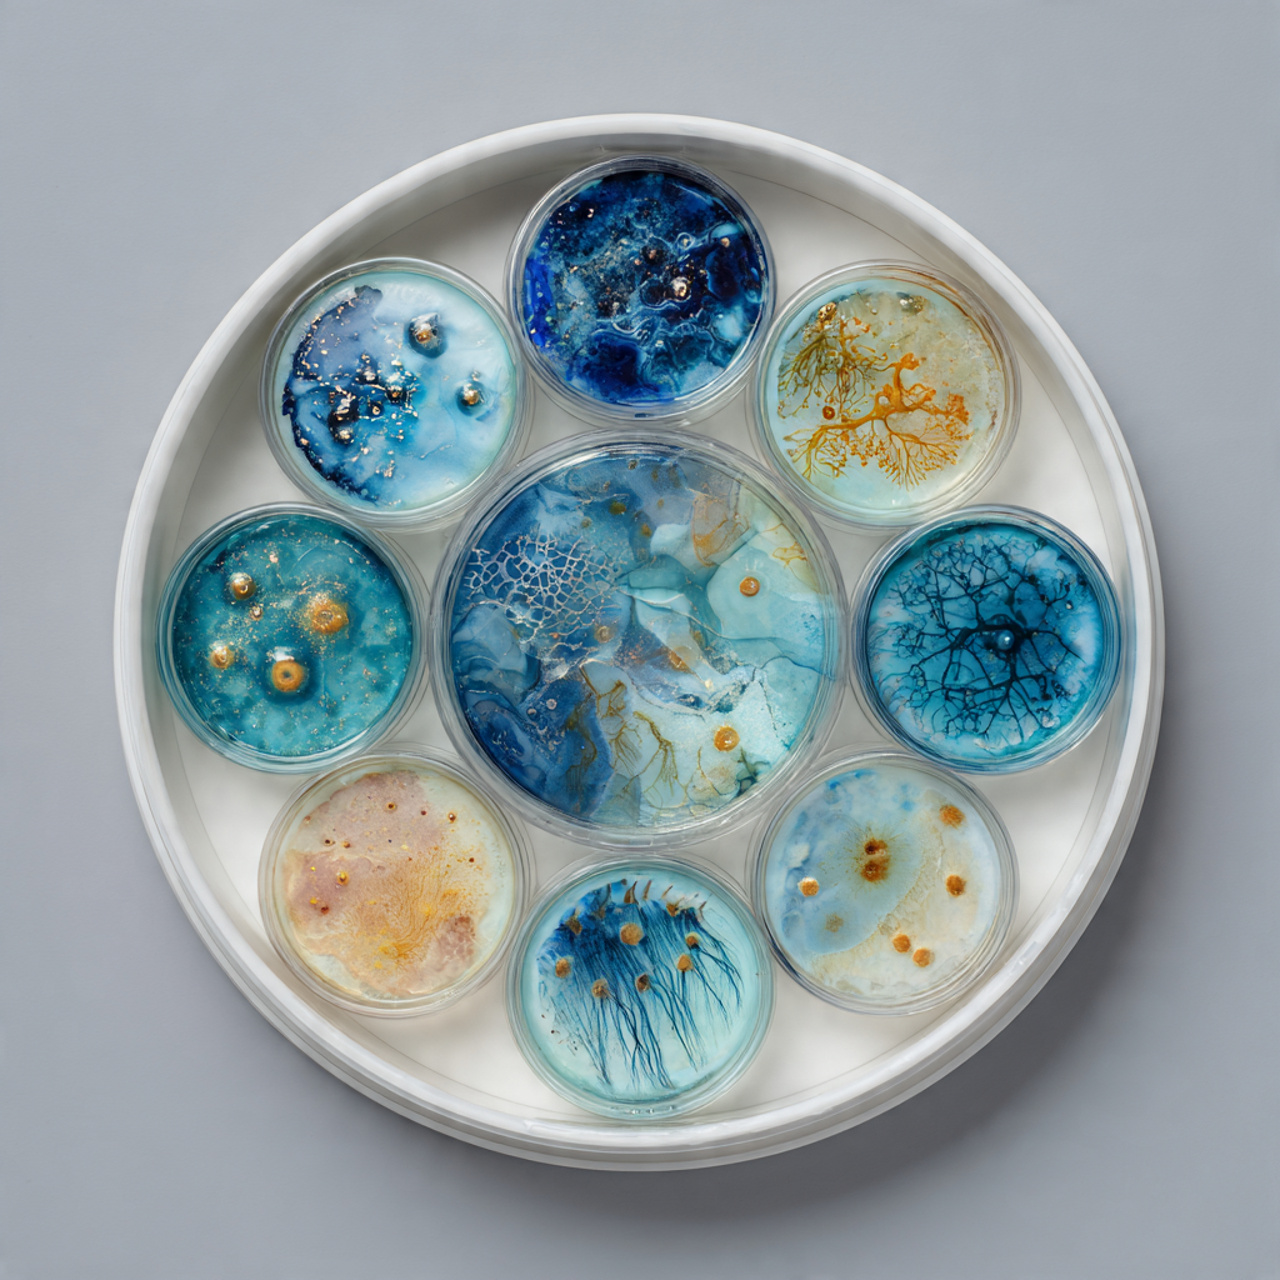

Browse Categories
- food packaging
- beverage packaging
Coffee CupsCold Drink CupsCup AccessoriesIce Cream PackagingBottle & Label Packaging
- eco-freindly packaging
Compostable PackagingRecyclable PackagingBiodegradable ProductsPaper AlternativesWooden ProductsSustainable Branding
- retail packaging
Protective PackagingLabels & StickersCustom Branding Finishes
- commercial printing
Business PrintingMarketing MaterialsRestaurant PrintingLarge Format PrintingCorporate PrintingPromotional Printing
- trophies
Sports TrophiesCorporate TrophiesSchool TrophiesAcrylic TrophiesCrystal TrophiesCustom Trophies
- shields
Sports TrophiesCorporate TrophiesSchool TrophiesAcrylic TrophiesCrystal TrophiesCustom Trophies
- medals
Sports MedalsCorporate MedalsCustom Medals
- Plaques
Wall PlaquesRecognition Plaques
- Engraving Services
Laser EngravingIndustrial EngravingPersonalised GiftsTrophy EngravingCustom Engraving
- bulk and corporate services
Restaurant SupplyCorporate SupplyEvent SolutionsWholesale ServicesAustralia-Wide Delivery